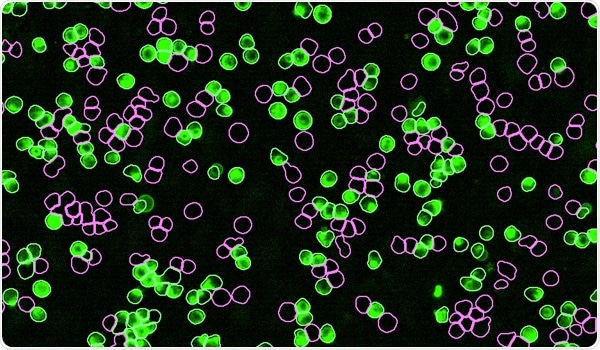
IncuCyte® SX1 Live-Cell Analysis System

The Incucyte® SX1 Live-Cell Analysis System available from Sartorius ensures automation at every step that fast-tracks users’ research and fits in their budget.
IncuCyte® SX1 Live-Cell Analysis System
Video Credit: Sartorius
Unparalleled access to live-cell insights
The present-day new normal necessitates achieving more with less. Users need data-rich, physiologically relevant cell analysis that is economical and streamlined. The new Incucyte® SX1 enables users to monitor their cells 24 hours a day.
Insight and accuracy at every step
Whether users just want to enhance experimental findings with improved cell culture quality control or intend to investigate complex cell-cell interactions, the Incucyte® can fulfill the needs of users. The system ensures a smooth transition from one step to the other in the workflow using exchangeable trays to assist dishes, multi-well plates, or tissue culture flasks.

Image Credit: Sartorius
Applications
Push the boundaries of R&D
Users can accelerate their next discovery using Incucyte®’s range of applications. They can also achieve the latest insights rapidly with a system developed for a variety of cell types, ranging from the proliferation of tumor cells to non-adherent immune cells to sensitive primary cells.
Incucyte®’s design includes a mobile optical train with continuous incubation. Users can carry out real-time cell surveillance and monitoring of migration and invasion, cell health and viability, and an extensive variety of phenotypic cell-based assays. With an increasingly growing collection of more than 2,800 peer-reviewed articles, the latest applications using the Incucyte® are being reported constantly.

Image Credit: Sartorius
Research areas
Incucyte® unlocks discoveries in a wide variety of research areas, such as immuno-oncology and oncology.
Image Credit: Sartorius
Applications
Incucyte® opens new understanding with an extensive variety of applications considering cell function, cell health, and many more.

Image Credit: Sartorius
Live Cell Insights publications newsletter
Users can keep up with the new Incucyte® research by reading Sartorius’ summaries of new and notable research articles featuring the Incucyte®.
Features
Research continues day and night with Incucyte®’s strong and automated workflow.
1. Simple, flexible sample preparation
- Adaptable with an extensive variety of culture vessels and applications
- Optimize efficiency while decreasing artifacts with Incucyte® Reagents
2. Set up and walk away
- Networked and remote access
- Streamlined experimental configuration
3. Acquire and view images over time
- Reduce cell disturbance with a mobile optical train
- HD phase and fluorescence imaging modes
4. Analyze in real-time
- Strong visualization of images and kinetic measurements
- Reproducible and efficient image analysis

Image Credit: Sartorius